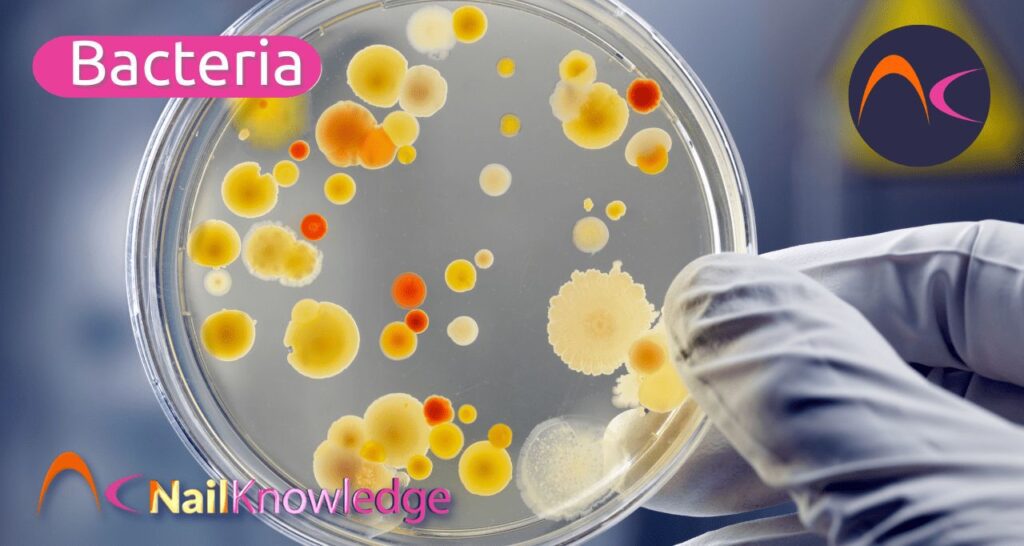

Há muitas espécies de bactérias em todo o mundo. Há bactérias tanto dentro quanto fora do corpo humano. Muitas são boas para você, mas algumas não são. Algumas podem deixá-lo doente. Uma espécie de bactéria relativamente comum em unhas é uma espécie de pseudomonas, também conhecida como "greenies". As "ruins" podem ser classificadas como patogênicas, mas os profissionais de unhas devem usar protocolos de higiene rigorosos para evitar que qualquer tipo de bactéria infecte seus clientes.